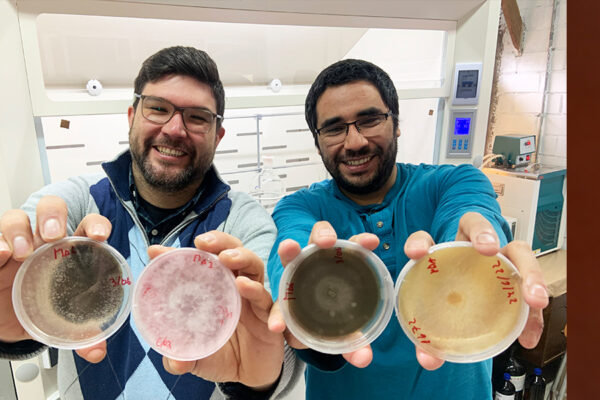

La investigación del Centro de Investigación e Innovación en Gerontología Aplicada (CIGAP) de Santo Tomás postula que las proteínas de personas con Síndrome Metabólico presentan anomalías dependientes de la edad, afectando principalmente la función cognitiva y propiciando enfermedades neurodegenerativas. Leer Más